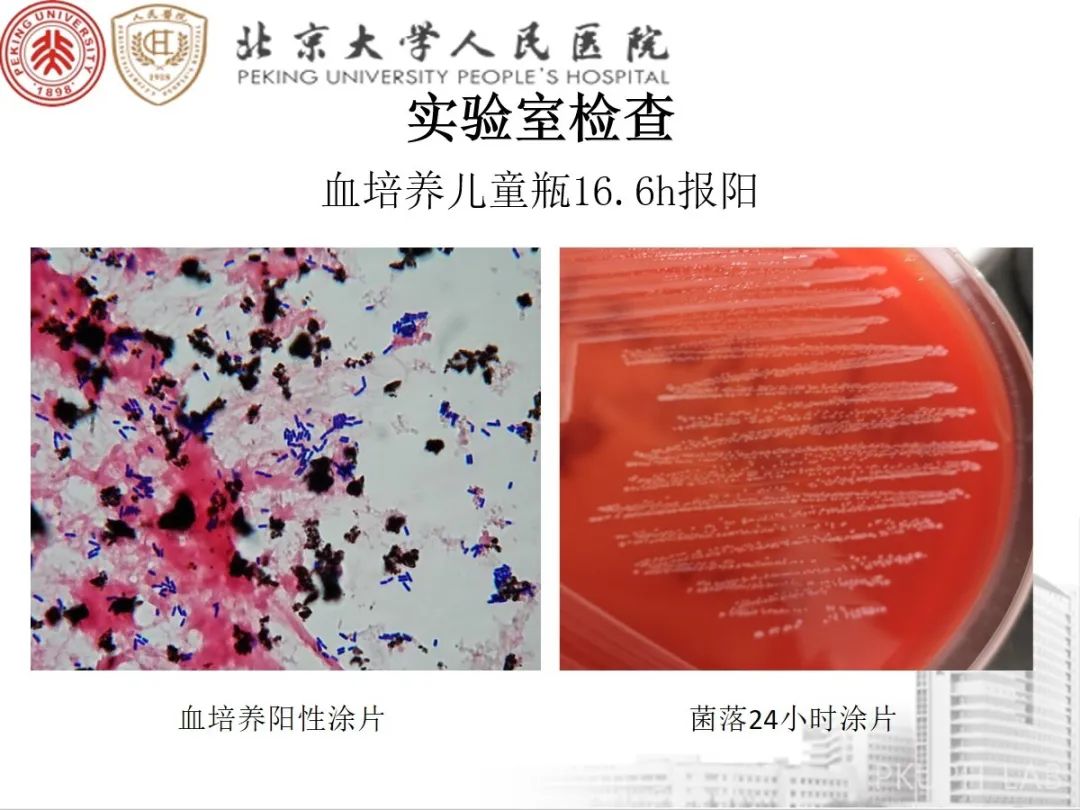

200
评论
查看更多
密码过期或已经不安全,请修改密码
修改密码
壹生身份认证协议书
同意
拒绝
同意
拒绝
同意
不同意并跳过
少见菌介绍——单核细胞增生李斯特菌

作者 北京大学人民医院 肖扬、孟涵
本文首发自pkuph检验科
查看更多